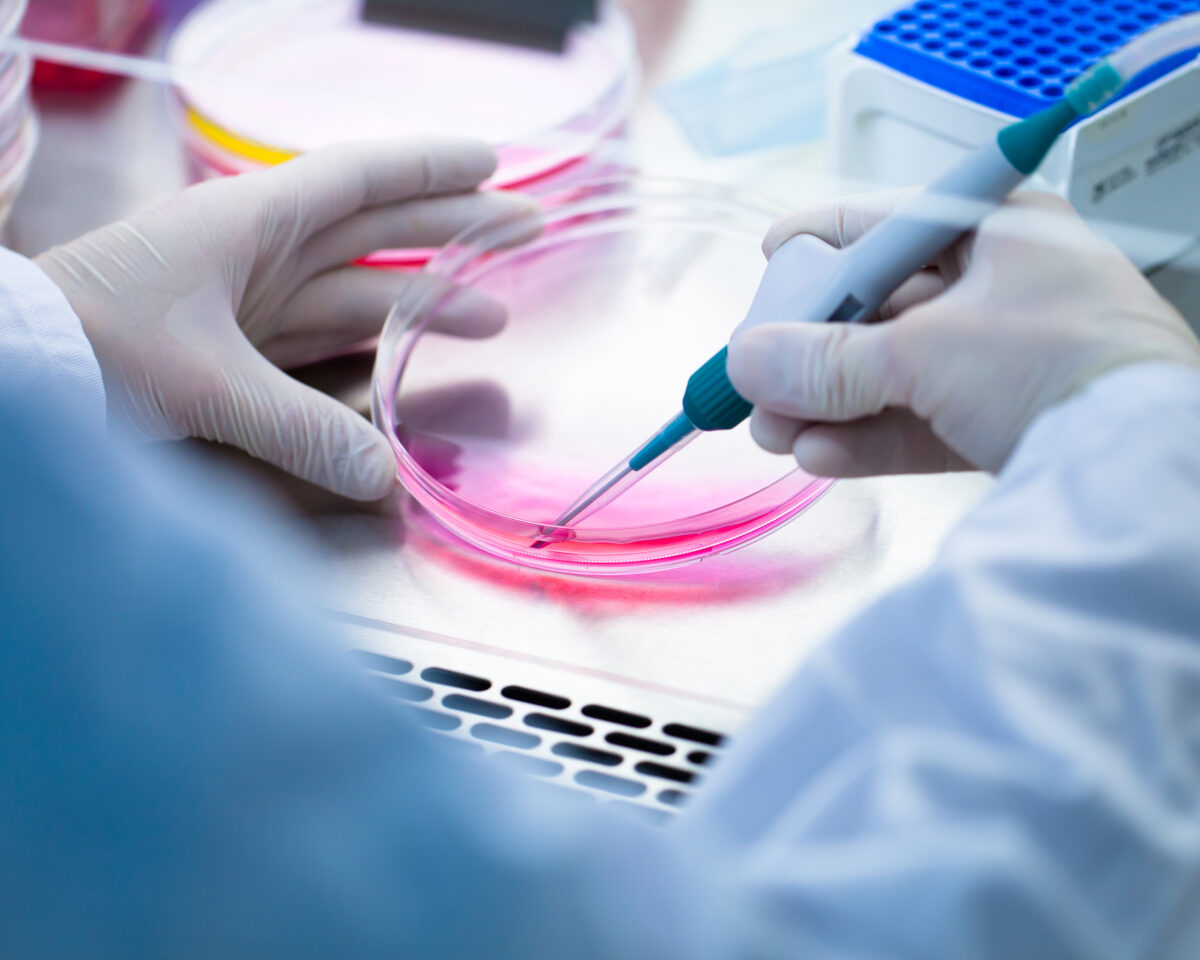

Sağlık optimizasyonuna hoş geldiniz!
Bir biohacker olarak beden ve zihin performansımı iyileştirip, yaşam kalitemi artırmak için en yüksek kalitedeki ürünleri, cihazları birebir deneyimliyorum. LongeviShop online alışveriş platformundaysa, tüm bu ürün ve cihazlardan en beğendiklerimi sizler için bir araya getiriyorum.
LongeviShop’ta tıpkı benim gibi, her zaman en iyisini tercih eden, zamanı kıymetli olan, pratik ve güvenilir alışveriş yapmak isteyen kişiler için ürünler yer alıyor. Anti-aging cilt bakım formüllü ürünlerden hücresel sağlık, beyin sağlığı ürün/cihazlarına ve vitamin takviyelerine dek uzanan, uzun ve sağlıklı bir yaşam için ihtiyacınız olan en yeni ve en iyi kalitede ürünlerin orijinal link’leri, siz longevity tutkunlarını bekliyor!
LongeviShop online mağazadaki her ürün, bir satıcı web sitesine bağlantı verir ve çoğu durumda özel indirim kodu sunar.